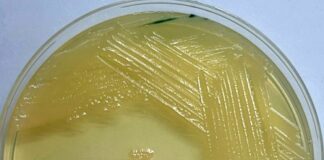
Nuevos Conocimientos Una nueva generación de antibióticos se alista para combatir a las superbacterias

Etiqueta: Antibióticos
NUEVOS CONOCIMIENTOS Antibióticos en piscicultura: la delgada línea entre crecimiento y...
Un estudio realizado como parte de una tesis doctoral en la UNNE analizó cómo el uso prolongado de antibióticos en la cría de Pacú...
Nuevos Conocimientos Una nueva generación de antibióticos se alista para combatir...
¿Estamos preparados para la próxima pandemia?. Especialistas advierten que la resistencia a los antibióticos podría desencadenar la próxima crisis de salud mundial. La medicina...
NUEVOS CONOCIMIENTOS Buscarán bacterias resistentes a antibióticos en peces del río...
La resistencia antimicrobiana a antibióticos es un tema central para la OMS. La estudiante de Veterinaria, María Giordano Basnec, propuso una línea de investigación con...
Entrevista Las superbacterias toman protagonismo ante la progresiva ineficacia de los...
Se estimaba que en el 2050 habría unas 10 millones de muertes atribuibles a todo tipo de infecciones sin que los antibióticos ejerzan su...